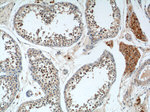
NGRN Antibody in Immunohistochemistry (Paraffin) (IHC (P))

Search
Proteintech
NGRN Polyclonal Antibody
{{$productOrderCtrl.translations['antibody.pdp.commerceCard.promotion.promotions']}}
{{$productOrderCtrl.translations['antibody.pdp.commerceCard.promotion.viewpromo']}}
{{$productOrderCtrl.translations['antibody.pdp.commerceCard.promotion.promocode']}}: {{promo.promoCode}} {{promo.promoTitle}} {{promo.promoDescription}}. {{$productOrderCtrl.translations['antibody.pdp.commerceCard.promotion.learnmore']}}
产品信息
14885-1-AP
种属反应
已发表种属
宿主/亚型
分类
类型
抗原
偶联物
形式
浓度
规格
纯化类型
保存液
内含物
保存条件
运输条件
产品详细信息
Immunogen sequence: MEAPGAPPR TLTWEAMEQI RYLHEEFPES WSVPRLAEGF DVSTDVIRRV LKSKFLPTLE QKLKQDQKVL KKAGLAHSLQ HLRGSGNTSK LLPAGHSVSG SLLMPGHEAS SKDPNHSTAL KVIESDTHRT NTPRRRKGRN KEIQDLEESF VPVAAPLGHP RELQKYSSDS ESPRGTGSGA LPSGQKLEEL KAEEPDNFSS KVVQRGREFF DSNGNFLYRI (1-219 aa encoded by BC001682)
靶标信息
NGRN may be involved in neuronal differentiation.
仅用于科研。不用于诊断过程。未经明确授权不得转售。
生物信息学
蛋白别名: FI58Gm; m-Neugrin; Mesenchymal stem cell protein DSC92; Neugrin; neurite outgrowth associated protein; Neurite outgrowth-associated protein; Spinal cord-derived protein FI58G; unnamed protein product
基因别名: AW552001; DSC92; FI58G; HT020; Neugrin; NGRN
UniProt ID: (Human) Q9NPE2, (Rat) Q3T1H2, (Mouse) Q99KS2
Entrez Gene ID: (Human) 51335, (Rat) 499191, (Mouse) 83485